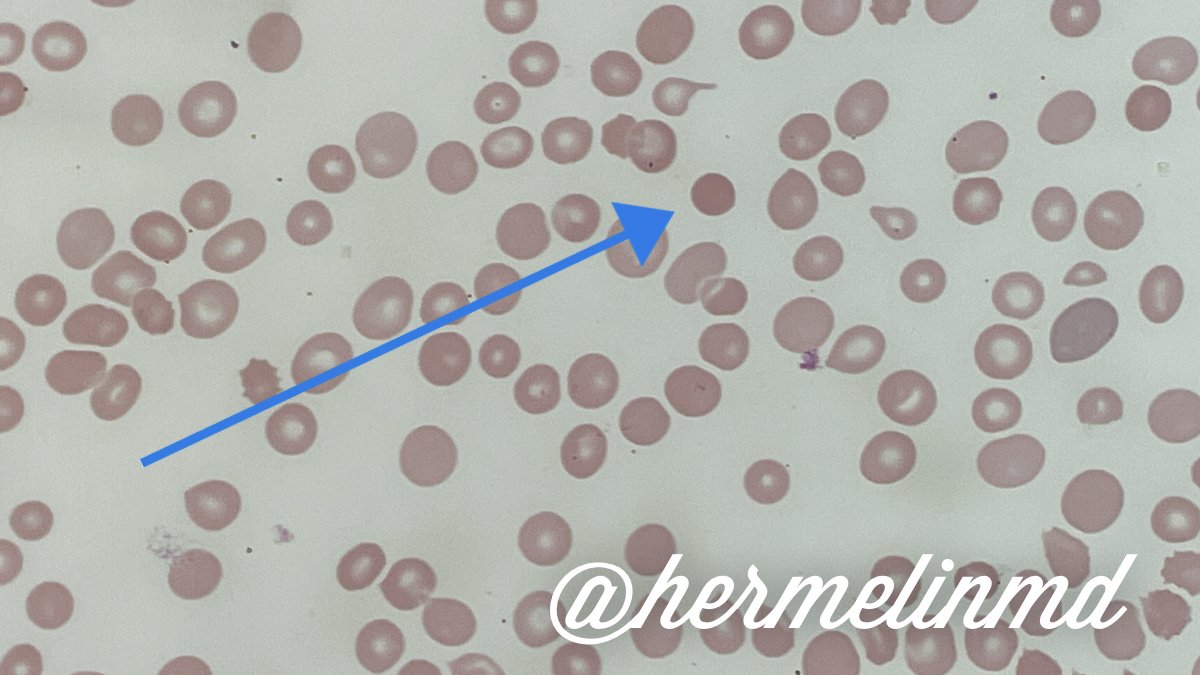

⁉️Based on these findings and the patient's clinical history, what could this antibody panel pattern indicate?
🙌🏽You got it! Based on the patient's clinical history of SLE (autoimmune disease), the patient most likely has an autoantibody reacting with all red blood cells causing a panreactive (panagglutinin) pattern.
⁉️What is the next step in testing?
⁉️What is the next step in testing?
👍🏽Right again! The next best step is to perform a DAT, also known as a Direct Coombs' Test which looks for antibody 🧥coating the red blood cell in vivo w/ IgG, complement, or both.
This patient's DAT was positive for IgG (3+) and negative for C3. The eluate showed evidence of a warm autoantibody.
⁉️What would help determine if this warm autoantibody is clinically significant meaning that it is causing hemolysis or contributing to the patient's anemia?
⁉️What would help determine if this warm autoantibody is clinically significant meaning that it is causing hemolysis or contributing to the patient's anemia?
To determine the clinical significance of the DAT, review hemolytic indices (H/H, Haptoglobin, LDH, Bilirubin, Retic Count) & the peripheral smear.
🔬The finding of #spherocytes will clench the diagnosis.
💡Keep in mind that the strength of the DAT is related to hemolysis.
🔬The finding of #spherocytes will clench the diagnosis.
💡Keep in mind that the strength of the DAT is related to hemolysis.
⁉️Will finding compatible blood be possible for this patient?
To learn more about this topic and how to treat #WAIHA, I highly recommend this great @ASH_hematology article 👉🏽How I treat warm autoimmune hemolytic anemia | Blood | American Society of Hematology ashpublications.org
Also, check out @WAIHAWarriors and provide this resource to your patients which is the first community built specifically for patients and caregivers who live with warm autoimmune hemolytic anemia. 👉🏽 waihawarriors.org
Loading suggestions...